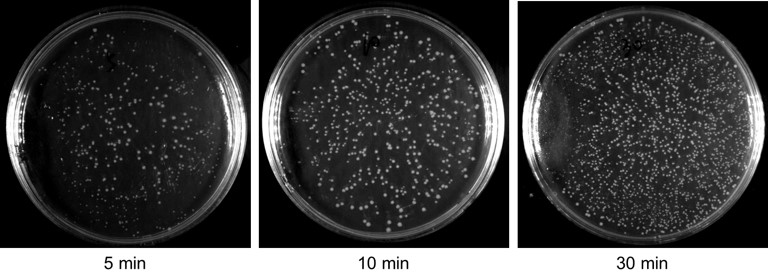
产品细节图片4

相关产品推荐更多 >
万千商家帮你免费找货
0 人在求购买到急需产品
- 详细信息
- 文献和实验
- 技术资料
- 规格:
10次
碧云天研发生产的BeyoCRISPR™ Surrogate GFP Reporter构建试剂盒,英文名称为BeyoCRISPR™ Surrogate GFP Reporter Construction Kit,也称BeyoCRISPR™基因编辑GFP替身报告基因构建试剂盒或BeyoCRISPR™ Gene-editing Surrogate GFP Reporter Construction Kit,是基于替身报告基因(Surrogate Reporter)研发的,用于构建能有效示踪或富集发生有效基因编辑的GFP替身报告质粒的试剂盒。
通常对细胞进行基因编辑的时候效率不会太高,仅部分细胞发生基因编辑,但哪些细胞发生基因编辑缺乏有效的活细胞示踪方法。本试剂盒通过替身报告基因(Surrogate Reporter)技术,用户仅需按照使用说明设计并合成gRNA靶向的基因组DNA序列(合成单链DNA后退火而成),连接至本试剂盒提供的线性化载体中,就可构建成可用于基因编辑细胞示踪或富集的替身报告质粒。替身报告基因质粒与表达Cas9及sgRNA的质粒共转染哺乳动物细胞后,可以直接通过检测细胞中的GFP荧光信号来确定该细胞中是否发生了有效的基因编辑。后续也可以通过流式细胞仪分选出GFP阳性细胞,从而获得高比例的基因编辑细胞,并用于下一步实验。由于替身报告基因质粒上含有和靶基因组相同的DNA序列,因此当替身报告基因发生基因的移码突变从而到GFP表达时,通常该细胞中也会发生基因组DNA的基因编辑,这样就可以根据GFP荧光信号有无来判定该细胞是否发生了基因编辑,同时也能初步判定该细胞的基因组DNA是否存在较高概率发生基因编辑。
本试剂盒基于替身报告基因(Surrogate Reporter)技术,将与靶基因序列一致的外源片段定向非移码非终止性插入至预先设计的本试剂盒提供的载体中,而载体中包含仅在发生基因编辑并且导致移码时才可表达的GFP报告基因,由此构建的替身报告质粒与能表达Cas9和sgRNA的质粒共转染时,可通过绿色荧光直观显示发生基因编辑的细胞,因此把这类报告基因命名为替身报告基因(Surrogate Reporter)。有研究表明,当细胞中某一染色体上的目标序列被CRISPR/Cas9、TALEN或ZFN等核酸酶突变时,同一细胞中另一条同源染色体上的相同目标序列发生突变的频率更高[1,2]。基于这一原理,可进一步通过流式细胞技术富集GFP阳性细胞,从而大幅提升获得基因编辑细胞的概率。
本试剂盒中提供的Linearized pCMV-RFP-STOP-GFP由编码两种荧光蛋白(RFP和GFP)的基因组成,RFP和GFP中间包含了待插入的sgRNA的靶向序列、PAM序列以及一个终止密码子连接(图1)。
pCMV-RFP-STOP-GFP质粒图谱如下。

图1.碧云天BeyoCRISPR™基因编辑Surrogate GFP Reporter构建试剂盒(D8403)中pCMV-RFP-STOP-GFP质粒图谱。
pCMV-RFP-STOP-GFP质粒为卡那霉素抗性。
pCMV-RFP-STOP-GFP质粒推荐的测序引物为:5'-AGATCAAGATGAGGCTGAAG-3'
在未发生基因编辑的情况下,GFP基因序列处于表达框外,细胞仅表达处于表达框内的红色荧光蛋白。当Cas9及相应sgRNA一起表达,并且发生基因编辑时,Cas9通过sgRNA靶向识别两个荧光蛋白之间插入的特异性替身序列,诱导靶位点双链断裂,并在修复后发生移码突变,使终止密码子因为移码而失效,导致原本处于表达框外的GFP移码至与RFP同一表达框内,从而导致细胞中红色荧光蛋白和绿色荧光蛋白的双重表达,实现基因编辑的示踪检测(图2)。后续可以通过流式细胞仪进一步富集RFP/GFP双阳性细胞,从而大幅提升基因敲除细胞的获得效率,实现相应的基因编辑细胞的快速富集。

图2.碧云天BeyoCRISPR™基因编辑Surrogate GFP Reporter构建试剂盒(D8403)构建的替身报告质粒的基因编辑示踪效果图。转染前一天,将稳定过表达Cas9的HEK293T细胞接种至24孔板中。细胞密度70%左右时,使用碧云天Lipo8000™转染试剂(C0533)将150ng带有特异性靶向序列的替身报告基因质粒分别与300ng非靶向的对照sgRNA (sgRNA-Control)或编码靶向sgRNA (sgRNA-Target)的质粒进行共转染。转染约48小时后,仅在转染靶向sgRNA质粒的细胞中同时观察到RFP及GFP荧光信号,GFP荧光信号的产生来自发生基因编辑的细胞。实际检测效果会因实验条件的不同而存在差异,图中效果仅供参考。
CRISPR/Cas9是一项突破性的基因组编辑技术,操作便捷,应用广泛。CRISPR (Clustered regularly interspaced short palindromic repeats)是一种原核生物利用RNA引导的DNA核酸酶Cas9对外源的噬菌体或病毒核酸进行基因沉默的获得性免疫系统(Adaptive immune system),后续在此基础上逐渐发展为广泛应用于原核和真核生物的越来越成熟的基因编辑技术。该技术能够在gRNA引导下通过Cas9对原核和真核生物的基因组DNA的靶向序列进行位点特异性的切割,然后通过易错修复(Error-prone repair)或同源重组(Homologous recombination)在切割位点改变或插入序列来产生移码突变,从而通过基因编辑而实现基因敲除。其中gRNA确保识别位点的特异性。随着CRISPR技术的发展,该技术目前不仅可以实现基因敲除,还可以实现基因的点突变、插入突变等多种突变方式,特别是在临床应用方面可以用于修复不良突变等[3,4]。同时通过构建没有内切酶活性的Cas9突变体dCas9,通过与dCas9直接融合表达或间接招募转录激活或转录抑制因子,可以实现sgRNA靶向基因的转录激活或转录抑制。
CRISPR/Cas9系统由Cas9 Nuclease和gRNA复合物所组成。gRNA,也称sgRNA (Single guide RNA),由18-20bp与靶基因序列互补的CRISPR RNA (crRNA)序列以及能与Cas9特异性结合的Trans-activating crRNA (tracrRNA)序列组成。gRNA通过与靶序列之间的互补配对,将Cas9 Nuclease引导至靶DNA,Cas9 Nuclease C端的与PAM (Proto-spacer adjacent motif)相互作用的结构域(PAM-interacting domain)识别富含G碱基(5'-NGG-3')的PAM序列,在HNH和RuvC两个结构域的协同作用下,在PAM序列NGG上游大约三个碱基处产生DNA的双链断裂(Double-strand break, DSB)。如果该双链DNA断裂发生在细胞内,在细胞DNA修复过程中会导致基因靶位点处的插入、删除或替换,从而可能产生移码突变,导致目的基因的缺失突变(图3) [4]。

图3.CRISPR/Cas9基因编辑示意图。
本试剂盒特别高效。本试剂盒提供超快速DNA连接酶,在25℃条件下连接5分钟即可在后续实验中获得较多克隆菌落,且克隆阳性率可达100%。本试剂盒的连接效果如图4所示。
本试剂盒使用便捷。本试剂盒提供线性化的载体,用户仅需将设计的Target-specific DNA oligos按照说明进行退火及连接即可进行转化涂板,无需额外的载体处理步骤,快速便捷。
本试剂盒仅用于替身报告质粒的快速构建,不包含任何编码Cas9及sgRNA的质粒。推荐使用碧云天BeyoCRISPR™ Quick Construction Kit (Puro) (D7087)进行Cas9/sgRNA编码质粒的快速构建。如需额外获取更多Cas9及sgRNA相关质粒或稳定表达Cas9的细胞株,请在碧云天网站查询或参考相关产品。
碧云天同时提供未线性化的替身报告基因载体质粒pCMV-RFP-STOP-GFP (Surrogate Reporter) (D8414)及基于替身报告基因的可用于sgRNA效率快速筛选的完整质粒试剂盒BeyoCRISPR™ sgRNA筛选试剂盒(替身报告基因法) (D8407)。
图4.使用碧云天BeyoCRISPR™基因编辑Surrogate GFP Reporter构建试剂盒(D8403)连接ds Oligo后转化DH5α感受态细胞后涂板获得的LB平板的效果图。结果表明,使用本试剂盒在25ºC连接5分钟即可得到较多的克隆数,且测序结果表明克隆阳性率几乎为100%。实际检测效果会因实验条件的不同而存在差异,图中效果仅供参考。
按推荐的体系进行操作,每个小包装本产品可以用于10次GFP替身报告质粒的构建。
包装清单:
| 产品编号 | 产品名称 | 包装 |
| D8403S-1 | Linearized pCMV-RFP-STOP-GFP (30ng/µl) | 20µl |
| D8403S-2 | Ultrapure Water | 2ml |
| D8403S-3 | Quick Ligase | 20µl |
| D8403S-4 | 10X Quick Ligation Buffer | 100µl |
| D8403S-5 | Primer-F (10µM) | 50µl |
| - | 说明书 | 1份 |
保存条件:
-20ºC保存,两年有效。
注意事项:
本试剂盒构建的替身报告质粒中包含RFP及GFP,其中GFP为报告基因,因此与其共转染的Cas9或sgRNA编码质粒中不能带有GFP或其它具有相近激发/发射光谱的荧光蛋白如YFP等。
对于普通的转化大肠杆菌的操作,不必对连接产物进行纯化,连接产物可以直接用于转化。但用电转方法转化大肠杆菌时,通常宜先用DNA纯化试剂盒或酚氯仿抽提方法等纯化DNA,然后再进行电转。
普通连接反应不必进行凝胶电泳观察。如果需要对于连接产物进行凝胶电泳观察,推荐先在65ºC孵育10分钟使Quick Ligase失活,以避免Quick Ligase和DNA结合导致的条带位置迁移(Band shift)。
本产品仅限于专业人员的科学研究用,不得用于临床诊断或治疗,不得用于食品或药品,不得存放于普通住宅内。
为了您的安全和健康,请穿实验服并戴一次性手套操作。
风险提示:丁香通仅作为第三方平台,为商家信息发布提供平台空间。用户咨询产品时请注意保护个人信息及财产安全,合理判断,谨慎选购商品,商家和用户对交易行为负责。对于医疗器械类产品,请先查证核实企业经营资质和医疗器械产品注册证情况。
文献和实验有SMART cDNA 合成和文库构建到? TriplEx2 或者Creator 供体载体 pDNR-LIB所需的试剂。因为该试剂盒是特别针对文库构建来设计的,所以它与Clontech™ PCR-Select™cDNA 差减杂交试剂盒不能配合使用。 SMART PCR cDNA Synthesis Kit 可以用来与Clontech™ PCR-Select™ cDNA 差减技术一起使用。总RNA 不能直接用来做差减实验,但可以通过SMART PCR cDNA Synthesis Kit 来扩增出
Choice of Surrogate and Physiological Markers for Prenatal Gene Therapy
Surrogate genetically encoded markers have been utilized in order to analyze gene transfer efficacy, location, and persistence. These marker genes have greatly accelerated the development of gene transfer vectors for the ultimate application
ProcartaPlex Basic Kit(其中包含标准品与磁微球之外的所有试剂),成为自己专有试剂盒。 ●ProcartaPlex 定制试剂盒 可针对您选择的因子设计提供量身定制化的试剂盒。您只需提供所要研究的物种,样本类型和所用仪器,然后选择您所需的因子,就可以针对您的特定要求来构建并优化出一套自定义的分析试剂盒。 访问 ebioscience.com/ProcartaPlex 可了解更多关于特征化分析的详细信息以及产品的完整列表。 详情请联系欣博盛生物科技
技术资料暂无技术资料 索取技术资料











